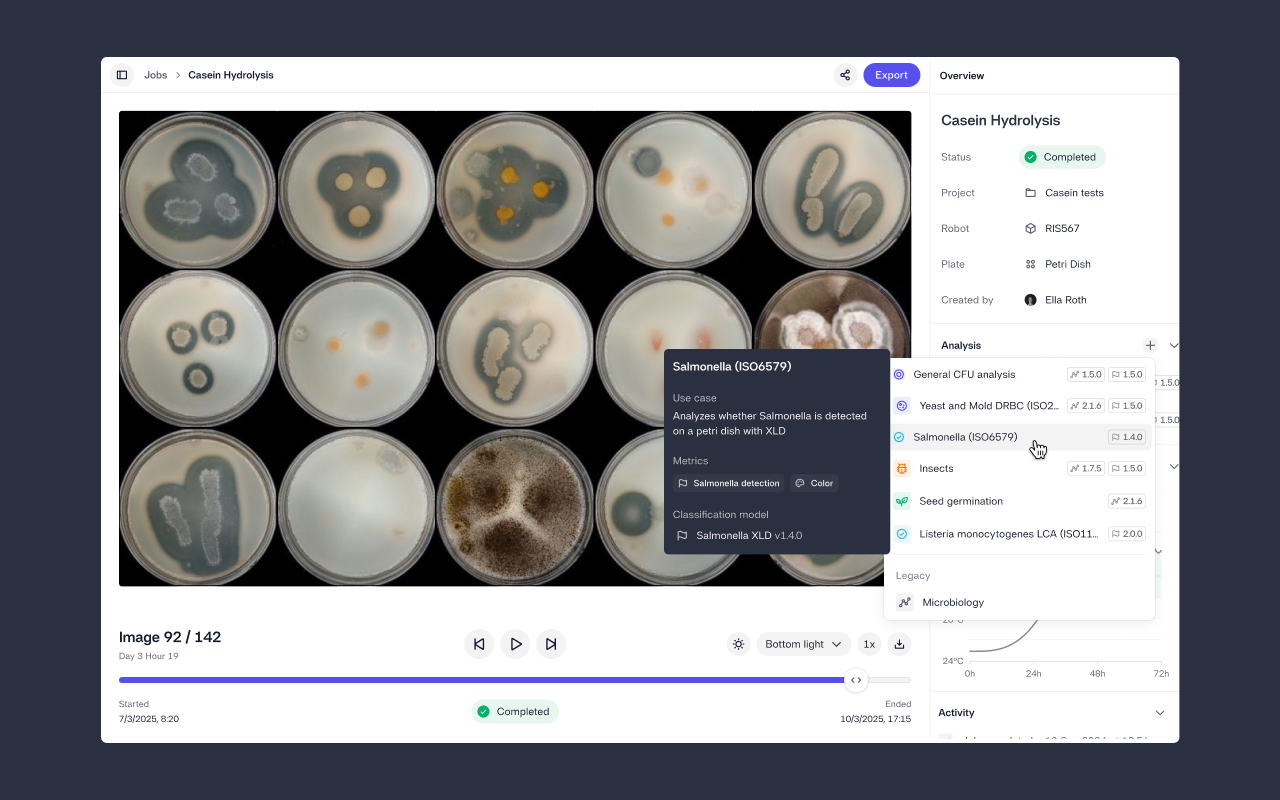
Add, update, and remove analyses from jobs

1771410984400
Tags for flexible job organization
by Mads Jersin
Feature Release
Improvement
Add flexible tags to jobs to organize, filter, and find experiments across assays, strains, and conditions without the need for a project folder.
1767955554223
Organism Library
by Mads Jersin
Explore how organisms behave across jobs and conditions with aggregated time-of-appearance insights, helping you compare, optimize, and design more effective assays.
1767788019759
Plate Designer (in Beta)
by Mads Jersin
Design plate layouts directly in Reshape before starting a job, with consistent metadata that improves reproducibility and downstream analysis.
1765533058988
Multi-factor authentication (MFA) for added account security
by Mads Jersin
Feature Release
Improvement
You can now enable multi-factor authentication to add an extra layer of protection to your Reshape account beyond your password.
1765442840202
Bulk edit well/plate properties
by Mads Jersin
You can now add well/plate properties in bulk, making it much faster to assign things like organism, media, and treatment across an entire tray and surface deeper insights from your experiments.
1764061203940
Add, update, and remove analyses from jobs
by Mads Jersin
You can now adjust which analyses run on a job yourself, making it faster to correct setups, update, and explore additional analyses.
1762172898750
Expanded Media Export + API
by Mads Jersin
Improvement
Feature Release
Media export options have been expanded to give you more flexibility, and media is now available for export via our API.
1761124762382
Secure, seamless sign-in with SAML SSO
by Mads Jersin
You can now sign in to Reshape using your organization’s existing credentials – simplifying access, improving security, and reducing IT management overhead.
1744633884965
Validate Your Analysis Results
by Mads Jersin
Now, you can add manual counts to colony jobs to verify analysis results, speed up model review, and build more trust in performance – all inside Reshape.